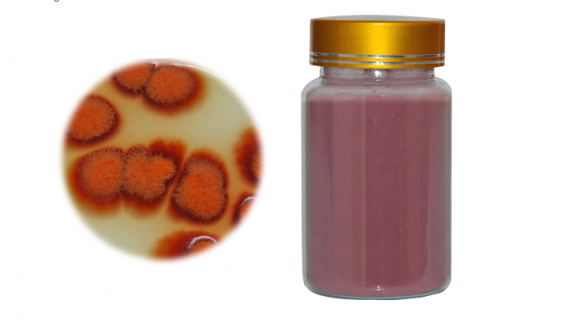

Looking for red yeast rice powder online? We are available with so many numbers of food products that you have not seen in such quality. If you choose to buy red yeast rice powder then you can sense the high-quality.
http://www.qualityherb.net/product/red-yeast-rice-powder.html